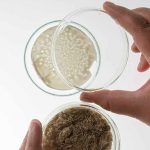

STOCKHOLM, SWEDEN — The world’s largest innovation challenge to transform the fashion industry is now open for applications. The Global Change Award 2022 is seeking early-stage innovations contributing to a planet positive fashion industry by addressing the earth’s global commons: land, water, oceans, climate, and biodiversity. Winners get to share a grant of 1 million euro, provided by the H&M Foundation.
The Global Change Award was initiated in 2015 by non-profit H&M Foundation, in collaboration with Accenture and the KTH Royal Institute of Technology. The award has attracted more than 20,000 entries since the start and several winners have gone on to collaborate with major industry actors. After a brief pause due to the pandemic, the innovation challenge now returns. For the 6th edition we are changing the scope, where we previously recognised ideas that can make the fashion industry circular we are now looking for solutions that address one or several of the global commons to create a planet positive fashion future. The GCA is all about speed, scale and impact and we are now raising the bar and taking a more holistic approach in order for the fashion industry to achieve radical change before 2030 and fulfil the UN Sustainable Development Goals.
“We believe focusing on land, water, oceans, climate, and biodiversity will lead to a true shift for the fashion industry, transforming this industry into a planet positive one. With all creative innovations out there ready to scale, there is real hope that the fashion industry can become truly sustainable. We are really excited to see what applications we will get as we gear up and launch this new scope.”
– Erik Bang, Innovation Lead H&M Foundation
A panel of experts will select five winners who get to share a 1 million euro grant and get access to our year-long GCA Impact Accelerator. The latter is designed to enable accelerated scaling of ideas and brings winners invaluable coaching and support along with a fierce network of brilliant minds and memories for life. The application period runs from 25 August 2021 to 20 October 2021 and the winners will be announced in April 2022.
“The fashion industry urgently needs to absorb game-changing planet positive solutions. We want to help speed up this process by supporting early-stage innovations and make them available to the wider market.”
– Karl-Johan Persson, board member of H&M Foundation and Chairman of H&M Group